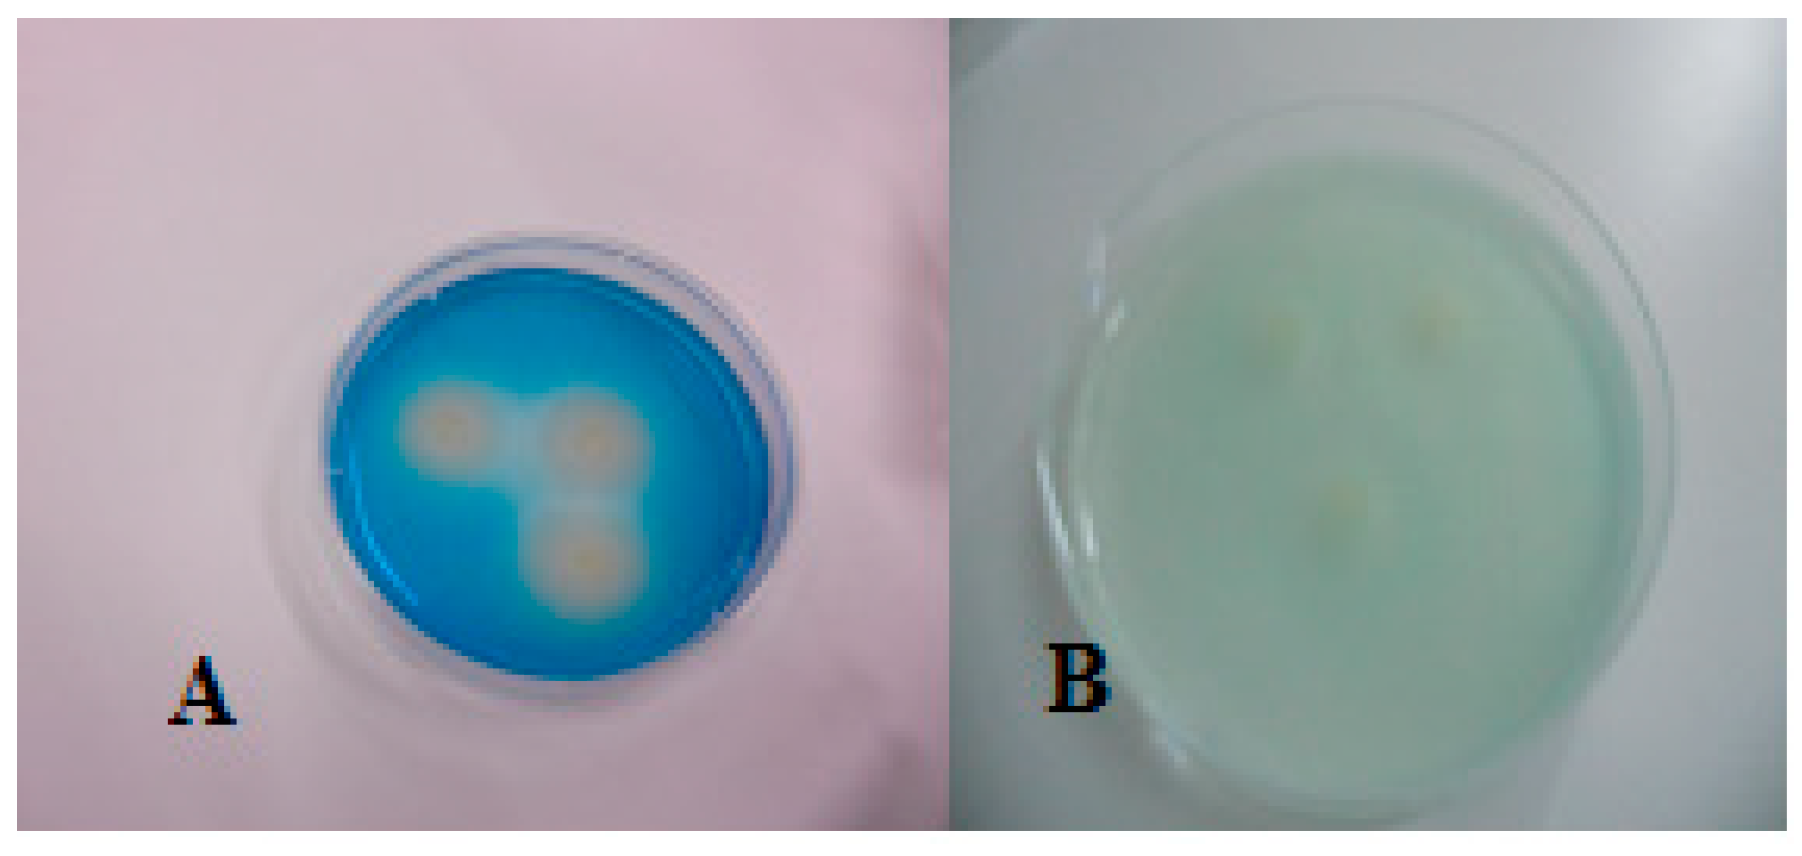
Applsci 14 00953 g004

Distinctive Culture Expressions of Enterobacteria Interfering with Isolation of Salmonella spp. during the Application of the Recommended ISO 6579-1:2017
Abstract
1. Introduction
2. Materials and Methods
Samples, Isolation, and Serotyping of Salmonella spp.
3. Results
3.1. Phenotypic Expression of Salmonella Isolates on Selective Media
3.2. Phenotypic Appearance of Gram-Negative Isolates Other than Salmonella spp. on Salmonella-Selective Media
4. Discussion
- (i)
- The content and availability of the sulfur source and peptones of the culture media. Peptones themselves contain varying amounts of sulfur amino acids and partially oxidized sulfur compounds, potentially giving a false positive result.
- (ii)
- The commercial diagnostic media may also contain fermentable carbohydrates, resulting in the masking of H2S production by the production of acid during sugar fermentation either because it is repressed or because it cannot be detected.
- (iii)
- The ability of the microorganism to stimulate H2S-producing enzymes and its H2S-producing rate [51,55,57]. Some consider that the ability of an isolate to produce H2S is plasmid mediated [58,59,60,61,62], although the nature of the plasmid differs from isolate to isolate. This could be the reason that lactose-positive Salmonella spp. appeared giving negative (−) H2S production on XLD and SS agars, possibly influenced by fermentation [63]. In the present study, non-H2S-producing Salmonella and E. coli isolates were stimulated to produce H2S when cultured side by side with H2S-producing isolates. Perhaps, the ‘masking’ of H2S was overcome in synergy when lactose-negative and strong H2S-producing isolates were cultured side by side. However, false-negative results decrease the recovery of Salmonella spp. if ISO recommendations are strictly followed, which influences its diagnostic value.
Author Contributions
Funding
Institutional Review Board Statement
Informed Consent Statement
Data Availability Statement
Conflicts of Interest
References
- Majowicz, S.E.; Musto, J.; Scallan, E.; Angulo, F.J.; Kirk, M.; O’Brien, S.J.; Jones, T.F.; Fazil, A.; Hoekstra, R.M. The global burden of nontyphoidal Salmonella gastroenteritis. Clin. Infect. Dis. 2010, 50, 882–889. [Google Scholar] [CrossRef] [PubMed]
- 2. EFSA and ECDC (European Food Safety Authority and European Centre for Disease Prevention and Control). The European Union One Health 2021 Zoonoses Report. EFSA J. 2022, 20, e07666. [Google Scholar] [CrossRef]
- Pires, S.M.; de Knegt, L.; Hald, T. Estimation of the Relative Contribution of Different Food and Animal Sources to Human Salmonella Infections in the European Union; Scientific/Technical Report; European Food Safety Authority: Parma, Italy, 2011. [Google Scholar]
- Chaname Pinedo, L.; Mughini-Gras, L.; Franz, E.; Hald, T.; Pires, S.M. Sources and trends of human salmonellosis in Europe, 2015–2019: An analysis of outbreak data. Int. J. Food Microbiol. 2022, 379, 109850. [Google Scholar] [CrossRef] [PubMed]
- Alocilja, E.C.; Radke, S.M. Market analysis of biosensors for food safety. Biosens. Bioelectron. 2003, 18, 841–846. [Google Scholar] [CrossRef]
- Hurd, H.S.; McKean, J.D.; Griffith, R.D.; Rostagno, M.H. Estimation of the Salmonella enterica prevalence in finishing swine. Epidemiol. Infect. 2004, 132, 127–135. [Google Scholar] [CrossRef]
- Waltman, W.D.; Mallinson, E.T. Isolation of Salmonella from poultry tissue and environmental samples: A nationwide survey. Avian Dis. 1995, 39, 45–54. [Google Scholar] [CrossRef]
- ISO 6579-1:2017; Microbiology of the Food Chain—Horizontal Method for the Detection, Enumeration and Serotyping of Salmonella—Part 1: Detection of Salmonella spp. ISO (International Organization for Standardization): Geneva, Switzerland, 2017.
- European Food Safety Authority. Report of the Task Force on Zoonoses Data Collection on the analysis of the baseline survey on the prevalence of Salmonella in slaughter pigs, in the EU, 2006-2007. Part A. Salmonella prevalence estimates. EFSA J. 2008, 135, 1–111. [Google Scholar]
- European Food Safety Authority. Analysis of the baseline survey onthe prevalence of Salmonella in holdings with breeding pigs in the EU, 2008. Part A. Salmonella prevalence estimates. EFSA J. 2009, 7, 1–93. [Google Scholar]
- EFSA (European Food Safety Authority); Boelaert, F.; Papanikolaou, A.; Rizzi, V.; Stoicescu, A.-V. Manual for Reporting on Zoonoses and Zoonotic Agents, within the Framework of Directive 2003/99/EC, and on Some Other Pathogenic Microbiological Agents for Information Derived from the Year 2019; EN-1791; EFSA Supporting Publication: Parma, Italy, 2020; p. 63. [Google Scholar] [CrossRef]
- Eriksson, E.; Aspan, A. Comparison of culture, ELISA and PCR techniques for Salmonella detection in faecal samples for cattle, pig and poultry. BMC Vet. Res. 2007, 3, 21. [Google Scholar] [CrossRef]
- ISO 6579:2002/Amd 1:2007; Detection of Salmonella spp. in Animal Faeces and in Environmental Samples from the Primary Production Stage, Amendment 1, Annex D. In Microbiology of Food and Animal Feeding Stuffs. Horizontal Method for the Detection of Salmonella spp. International Organization for Standardization: Geneva, Switzerland, 2007.
- Baylis, C.L.; MacPhee, S.; Betts, R.P. Comparison of two commercial preparations of buffered peptone water for the recovery and growth of Salmonella bacteria from foods. J. Appl. Microbiol. 2000, 89, 501–510. [Google Scholar] [CrossRef]
- Zheng, Q.; Mikš-Krajnik, M.; D’Souza, C.; Yang, Y.; Heo, D.-J.; Kim, S.-K.; Lee, S.-C.; Yuk, H.-G. Growth of healthy and sanitizer-injured Salmonella cells on mug bean sprouts in different commercial enrichment broths. Food Microbiol. 2015, 52, 159–168. [Google Scholar] [CrossRef] [PubMed]
- Gracias, K.S.; McKillip, J.L. A review of conventional detection and enumeration methods for pathogenic bacteria in food. Can. J. Microbiol. 2004, 50, 883–890. [Google Scholar] [CrossRef] [PubMed]
- Zdragas, A.; Tsakos, P.; Mavrogeni, P. Evaluation of two assays, MSRV and RV, for the isolation of Salmonella spp. from wastewater samples and broiler chickens. Lett. Appl. Microbiol. 2000, 31, 328–331. [Google Scholar] [CrossRef] [PubMed]
- Read, S.C.; Irwin, R.J.; Poppe, C.; Harris, J. A comparison of two methods for isolation of Salmonella from poultry litter samples. Poult. Sci. 1994, 73, 1617–1621. [Google Scholar] [CrossRef] [PubMed]
- Davies, R.H.; Wray, C. Evaluation of a rapid cultural method for identification of salmonellas in naturally contaminated veterinary samples. J. Appl. Bacteriol. 1994, 77, 237–241. [Google Scholar] [CrossRef] [PubMed]
- Voogt, N.; Raes, M.; Wannet, W.J.; Henken, A.M.; van de Giessen, A.M. Comparison of selective enrichment media for the detection of Salmonella in poultry faeces. Lett. Appl. Microbiol. 2001, 32, 89–92. [Google Scholar] [CrossRef] [PubMed]
- Dam-Deisz, W.D.; Maas, H.M.; Nagelkerke, N.; van de Giessen, A.W. Comparison of selective enrichment media for the isolation of Salmonella spp. from faecal samples from fattening pigs, veal calves and dairy cows. De Ware(n) Chem. 2003, 3, 143–151. [Google Scholar]
- Manafi, M. New developments in chromogenic and fluorogenic culture media. Int. J. Food Microbiol. 2000, 60, 205–218. [Google Scholar] [CrossRef]
- Tate, C.R.; Miller, R.G.; Mallinson, E.T.; Douglass, L.W.; Johnston, R.W. The isolation of salmonellae from poultry environmental samples by several enrichment procedures using plating media with and without novobiocin. Poult. Sci. 1990, 69, 721–726. [Google Scholar] [CrossRef]
- Eigner, U.; Reissbrodt, R.; Hammann, R.; Fahr, A.M. Evaluation of a new chromogenic medium for the isolation and presumptive identification of Salmonella species from stool specimens. Eur. J. Clin. Microbiol. Infect. Dis. 2001, 20, 558–565. [Google Scholar] [CrossRef]
- Perry, J.D.; Ford, M.; Taylor, J.; Jones, A.L.; Freeman, R.; Gould, F.K. ABC medium, a new chromogenic agar for selective isolation of Salmonella spp. J. Clin. Microbiol. 1999, 37, 766–768. [Google Scholar] [CrossRef] [PubMed]
- Schönenbrücher, V.; Mallinson, E.T.; Bülte, M.A. comparison of standard cultural methods for the detection of foodborne Salmonella species including three new chromogenic plating media. Int. J. Food Microbiol. 2008, 123, 61–66. [Google Scholar] [CrossRef] [PubMed]
- Ruiz, J.; Núñez, M.L.; Lorente, I.; Pérez, J.; Simarro, E.; Gómez, J. Performance of six culture media for isolation of Salmonella species from stool samples. Eur. J. Clin. Microbiol. Infect. Dis. 1996, 15, 922–926. [Google Scholar] [CrossRef] [PubMed]
- Ruiz, J.; Nunez, M.L.; Diaz, J.; Lorente, I.; Perez, J.; Gomez, J. Comparison of five plating media for isolation of Salmonella species from human stools. J. Clin. Microbiol. 1996, 34, 686–688. [Google Scholar] [CrossRef] [PubMed]
- Perry, J.D.; Freydière, A.M. The application of chromogenic media in clinical microbiology. Lett. Appl. Microbiol. 2007, 103, 2046–2055. [Google Scholar] [CrossRef] [PubMed]
- Hyatt, D.R.; Weese, J.S. Salmonella Culture: Sampling procedures and laboratory techniques. Vet. Clin. N. Am. Equine Pract. 2004, 20, 577–585. [Google Scholar] [CrossRef]
- Evangelopoulou, G.; Kritas, S.; Govaris, A.; Burriel, A.R. Pork Meat as a Potential Source of Salmonella enterica subsp. arizonae Infection of Man. J. Clin. Microbiol. 2014, 52, 741–744. [Google Scholar] [CrossRef]
- Love, B.C.; Rostagno, M.H. Comparison of Five Culture Methods for Salmonella Isolation from Swine Fecal Samples of Known Infection Status. J. Vet. Diagn. Investig. 2008, 20, 620. [Google Scholar] [CrossRef]
- Davies, P.R.; Turkson, P.K.; Funk, J.A.; Nichols, M.A.; Ladely, S.R.; Fedorka-Cray, P.J. Comparison of methods for isolating Salmonella bacteria from faeces of naturally infected pigs. J. Appl. Microbiol. 2000, 89, 169–177. [Google Scholar] [CrossRef]
- Jensen, A.N.; Sørensen, G.; Baggesen, D.L.; Bødker, R.; Hoorfar, J. Addition of Novobiocin in pre-enrichment step can improve Salmonella culture protocol of modified semisolid Rappaport-Vassiliadis. J. Microbiol. Methods 2003, 55, 249–255. [Google Scholar] [CrossRef]
- Osumi, T.; Asai, T.; Namimatsu, T.; Sato, S.; Yamamoto, K. Enrichment for isolating Salmonella choleraesuis and other Salmonella spp. from pigs. J. Vet. Med. Sci. 2003, 65, 949–951. [Google Scholar] [CrossRef] [PubMed]
- Pangloli, P.; Dje, Y.; Oliver, S.P.; Mathew, A.; Golden, D.A.; Taylor, W.J.; Draughon, F.A. Evaluation of methods for recovery of Salmonella from dairy cattle, poultry, and swine farms. Evaluation of methods for recovery of Salmonella from dairy cattle, poultry, and swine farms. J. Food Prot. 2003, 66, 1987–1995. [Google Scholar] [CrossRef]
- Korsak, N.; Degeye, J.N.; Etienne, G.; China, B.; Daube, G. Comparison offour different methods for Salmonella detection in fecalsamples of porcine origin. J. Food Prot. 2004, 67, 2158–2164. [Google Scholar] [CrossRef] [PubMed]
- Champagne, M.J.; Ravel, A.; Daignault, D. A comparison of sample weight and culture methods for the detection of Salmonella in pig feces. J. Food Prot. 2005, 68, 1073–1076. [Google Scholar] [CrossRef] [PubMed]
- Mejia, W.; Zapata, D.; Mateu, E.; Martin, M. Lack of specificity of a combination of Rappaport-Vassiliadis broth and XLT4 agar for the isolation of salmonellae from pig faeces. Vet. Rec. 2005, 156, 150–151. [Google Scholar] [CrossRef] [PubMed]
- Rostagno, M.H.; Gailey, J.K.; Hurd, H.S.; Mckean, J.D.; Leite, R.C. Culture methods differ on the isolation of Salmonella enterica serotypes from naturally contaminated swine fecal samples. J. Vet. Diagn. Investig. 2005, 17, 80–83. [Google Scholar] [CrossRef] [PubMed]
- De Zutter, L.; De Smedt, J.M.; Abrams, R.; Beckers, H.; Catteau, M.; de Borchgrave, J.; Debevere, J.; Hoekstra, J.; Jonkers, F.; Lenges, J.; et al. Collaborative study on the use of motility enrichment on modified semisolid Rappaport-Vassiliadis medium for the detection of Salmonella from foods. Int. J. Food Microbiol. 1991, 13, 11–20. [Google Scholar] [CrossRef]
- Bauwens, L.; Vercammen, F.; Bertrand, S.; Collard, J.M.; De Ceuster, S. Isolation of Salmonella from environmental samples collected in the reptile department of Antwerp Zoo using different selective methods. J. Appl. Microbiol. 2006, 101, 284–289. [Google Scholar] [CrossRef]
- Koyuncu, S.; Haggblom, P. A comparative study of cultural methods for the detection of Salmonella in feed and feed ingredients. BMC Vet. Res. 2009, 5, 6. [Google Scholar] [CrossRef]
- Ewing, W.H. Differentiation of Enterobacteriaceae by biochemical reactions. In Edwards and Ewing’s Identification of the Enterobacteriaceae, 4th ed.; Elsevier Science Publishing Co., Inc.: New York, NY, USA, 1986; pp. 47–72. [Google Scholar]
- Falcao, D.P.; Trabulsi, L.R.; Hickman, F.; Farner, J.S. Unusual Enterobacteriaceae: Lactosepositive Salmonella typhimurium which is endemicin Sao-Paulo, Brazil. J. Clin. Microbiol. 1975, 2, 349–353. [Google Scholar] [CrossRef]
- Rokey, N.W.; Mecca, M.D. Lactose fermenting salmonellae—A dilemma for diagnostic laboratories? Proc. Annu. Meet. U.S. Anim. Health Assoc. 1972, 75, 509–514. [Google Scholar]
- Blackburn, B.O.; Ellis, E.M. Lactose-fermenting Salmonella from dried milk and milk-drying plants. Appl. Microbiol. 1973, 26, 672–674. [Google Scholar] [CrossRef] [PubMed]
- Johnston, K.G.; Jones, R.T. Salmonellosis in calves due to lactose fermenting Salmonella typhimurium. Vet. Rec. 1976, 98, 276–278. [Google Scholar] [CrossRef]
- MacDonald, C.; Riley, M. Cloning chromosomal lac genes of Klebsiella pneumoniae. Gene 1983, 24, 341–345. [Google Scholar] [CrossRef] [PubMed]
- McDonough, P.L.; Shin, S.J.; Lein, D.H. Diagnostic and Public Health Dilemma of Lactose-Fermenting Salmonella enterica Serotype Typhimurium in Cattle in the Northeastern United States. J. Clin. Microbiol. 2000, 38, 1221. [Google Scholar] [CrossRef] [PubMed]
- Barrett, E.L.; Clark, M.A. Tetrathionate Reduction and Production of Hydrogen Sulfide from Thiosulfate. Microbiol. Rev. 1987, 51, 192–205. [Google Scholar] [CrossRef]
- Ewing, W.H. Edwards and Ewing’s Identification of Enterobacteriaceae, 4th ed.; Elsevier: Amsterdam, The Netherlands, 1985; p. 192. [Google Scholar]
- Lannigan, R.; Hussain, Z. Wound Isolate of Salmonella typhimurium That Became Chlorate Resistant after Exposure to Dakin’s Solution: Concomitant Loss of Hydrogen Sulfide Production, Gas Production, and Nitrate Reduction. J. Clin. Microbiol. 1993, 31, 2497. [Google Scholar] [CrossRef]
- Sasahara, K.C.; Heinzinger, N.K.; Barrett, E.L. Hydrogen Sulfide Production and Fermentative Gas Production by Salmonella yphimurium Require F0F1 ATP Synthase Activity. J. Bacteriol. 1997, 179, 6736–6740. [Google Scholar] [CrossRef]
- Clarke, P.H. Hydrogen Sulphide Production by Bacteria. J. Gen. Microbiol. 1953, 8, 397407. [Google Scholar] [CrossRef]
- Leinweber, F.J.; Monty, K.J. The metabolism of thiosulphate in Salmonella typhimurium. J. Biol. Chem. 1963, 238, 3775–3780. [Google Scholar] [CrossRef]
- Rambach, A. New plate medium for facilitated differentiation of Salmonella spp. from Proteus spp. and other enteric bacteria. Appl. Environ. Microbiol. 1990, 56, 301–303. [Google Scholar] [CrossRef] [PubMed]
- Burkardt, H.J.; Mattes, R.; Schmid, K.; Schmitt, R. Properties of two conjugative plasmids mediating tetracyclineresistance, raffinose catabolism, and hydrogen sulfide production by Escherichia coli. Mol. Gen. Genet. 1978, 166, 75–84. [Google Scholar] [CrossRef] [PubMed]
- Lautrop, H.; Orskov, I.; Gaarslev, K. Hydrogensulphide producing variants of Escherichia coli. Acta Pathol. Microbiol. Scand. 1971, 79, 641–650. [Google Scholar] [CrossRef] [PubMed]
- Layne, P.; Hu, A.S.L.; Balows, A.; Davis, B.R. Extrachromosomal nature of hydrogen sulfide productionin Escherichia coli. J. Bacteriol. 1971, 106, 1029–1030. [Google Scholar] [CrossRef] [PubMed]
- Magalhies, M.; Veras, A. Properties of pPE1572(Hys-Raf), a plasmid governing hydrogen sulphide production and raffinose fermentation in Escherichia coli. J. Gen. Microbiol. 1977, 99, 445–447. [Google Scholar] [CrossRef] [PubMed]
- Orskov, I.; Orskov, F. Plasmid-determined H2S character in Escherichia coli and its relation to plasmid-carried raffinose fermentation and tetracycline resistance characters. Examination of 32 H2S-positive strains isolated during theyears 1950–1971. J. Gen. Microbiol. 1973, 77, 487–499. [Google Scholar] [CrossRef] [PubMed]
- Bulmash, J.M.; Fulton, M.; Jiran, J. Lactose and sulfide reactions of an aberrant Salmonella strain. J. Bacteriol. 1965, 89, 259. [Google Scholar] [CrossRef]
- Barbour, E.K.; Nabbut, N.H.; Al-Nakhli, H.M. Production of H2S by Escherichia coli isolated from poultry: An unusual character useful for epidemiology of colisepticemia. Avian Dis. 1985, 29, 341–346. [Google Scholar] [CrossRef]
- Darland, G.; Davis, B.R. Biochemical and serological characterization of hydrogen sulfide-positive variants of Escherichia coli. Appl. Microbiol. 1974, 27, 54–58. [Google Scholar] [CrossRef]
- Maker, M.D.; Washington, J.A.I.I. Hydrogensulfide-producing variants of Escherichia coli. Appl. Microbiol. 1974, 28, 303–305. [Google Scholar] [CrossRef]
- Carrique-Mas, J.J.; Davies, R.H. Sampling and bacteriological detection of Salmonella in poultry and poultry premises: A review. Rev. Sci. Tech. Off. Int. Epiz. 2008, 27, 665–677. [Google Scholar] [CrossRef] [PubMed]

| A/A | Isolate | MSRV | XLD | SS | BG | SCA | H2S | TSI | Antisera | Biochemical Profile |
|---|---|---|---|---|---|---|---|---|---|---|
| Typical Colonial Appearance | Whitish-Opaque Turbid Zones with a Diameter ≥ 30 mm | Red Colonies with or without Black Centers | Straw-Colored Colonies with Black Centers | Red-Pink-White Opaque Colonies | Magenta Colonies | |||||
| 1. | S.I.4,5,12:i:- | − | b | a | a | a | + | a | * | Salmonella spp. |
| 2. | S.I.4,5,12:i:- | − | a | a | a | a | + | a | * | Salmonella spp. |
| 3. | S.I.4,12:i:- | ††† | b | a | a | a | + | a | * | Salmonella spp. |
| 4. | S.I.4,12:i: | †††† | b | a | a | a | + | h | * | Salmonella spp. |
| 5. | S.I.4,12:i: | †††† | b | a | a | a | + | a | * | Salmonella spp. |
| 6. | S.I.6,14,25:-:1,2 | − | c | d | e | f | + | g | * | Salmonella spp. |
| 7. | S. enterica subsp. houtenae 40:g,t:- | † | c | d | e | f | + | g | * | Salmonella spp. |
| 8. | S. enterica subsp. salamae 38:b:1,2 | † | c | d | e | f | + | g | * | Salmonella spp. |
| 9. | S.I.6,7:k:- | † | c | d | e | a | + | g | * | E. coli |
| 10. | S.I.6,7:k:- | ††† | c | d | e | a | + | g | * | Salmonella spp. |
| 11. | S. Cerro | †† | a | a | a | a | + | h | * | E. coli inactive |
| 12. | S. enterica subsp. diarizonae 61:k:1,5 | ††† | a | a | a | a | + | h | * |
| A/A | ISOLATE | MSRV | XLD | SS | BG | SCA | H2S | TSI | Salmonella ANTISERA |
|---|---|---|---|---|---|---|---|---|---|
| 8. | E. coli | (−) | a | a | a | f | (+) | p | O(+), H(−) |
| 21. | E. coli | †† | m | r | a | f | (−) | s | light (+) for O and H antigens |
| 30. | E. coli | † | x | d | o | f | (−) | s | O(+), H(+) |
| 48. | E. coli | †† | a | a | a | f | (+) | p | O(+), H(−) |
| 52. | E. coli | ††† | a | a | a | f | (+) | a | O(+), H(+) |
| 76. | E. coli | ††† | b | r | a | f | (+) | p | O(+), H(−) |
| 77. | E. coli | ††† | a | a | a | f | (+) | p | O(+), H(−) |
| 80. | E. coli | †††† | a | a | a | f | (+) | p | light (+) for both O and H antigens |
| 81. | E. coli inactive | †† | a | a | a | f | (+) | p | light (+) for O and H antigens |
| 82. | †† | b | a | a | f | (+) | p | light (+) for O and H antigens | |
| 88. | E. coli (indole negative) | †† | y | t | o | f | (+) | p | light (+) for O and H antigens |
| 94. | E. coli | † | w | t | o | f | (+) | p | O(+), H(−) |
| 75. | Citrobacter freundii (indole negative) | ††† | y | d | o | f | (+) | p | light (+) for O and H antigens |
| 83. | Citrobacter freundii | ††† | b | d | e | f | (+) | p | light (+) for O and H antigens |
| 93. | Citrobacter freundii | ††† | b | a | a | f | (+) | p | light (+) for O and H antigens |
| 4. | Trabulsiella guamensis | †† | k | a | o | f | (+) | p | light (+) for O and H antigens |
| 90. | Trabulsiella guamensis | †† | y | t | o | f | (+) | p | O (light +), H(−) |
| 73. | Klebsiella ozanae | †† | z | a | o | f | (+) | p | O, H (−) |
Disclaimer/Publisher’s Note: The statements, opinions and data contained in all publications are solely those of the individual author(s) and contributor(s) and not of MDPI and/or the editor(s). MDPI and/or the editor(s) disclaim responsibility for any injury to people or property resulting from any ideas, methods, instructions or products referred to in the content. |
© 2024 by the authors. Licensee MDPI, Basel, Switzerland. This article is an open access article distributed under the terms and conditions of the Creative Commons Attribution (CC BY) license (https://creativecommons.org/licenses/by/4.0/).
Share and Cite
Evangelopoulou, G.; Burriel, A.R.; Solomakos, N. Distinctive Culture Expressions of Enterobacteria Interfering with Isolation of Salmonella spp. during the Application of the Recommended ISO 6579-1:2017. Appl. Sci. 2024, 14, 953. https://doi.org/10.3390/app14030953
Evangelopoulou G, Burriel AR, Solomakos N. Distinctive Culture Expressions of Enterobacteria Interfering with Isolation of Salmonella spp. during the Application of the Recommended ISO 6579-1:2017. Applied Sciences. 2024; 14(3):953. https://doi.org/10.3390/app14030953
Chicago/Turabian StyleEvangelopoulou, Grammato, Angeliki R. Burriel, and Nikolaos Solomakos. 2024. "Distinctive Culture Expressions of Enterobacteria Interfering with Isolation of Salmonella spp. during the Application of the Recommended ISO 6579-1:2017" Applied Sciences 14, no. 3: 953. https://doi.org/10.3390/app14030953
APA StyleEvangelopoulou, G., Burriel, A. R., & Solomakos, N. (2024). Distinctive Culture Expressions of Enterobacteria Interfering with Isolation of Salmonella spp. during the Application of the Recommended ISO 6579-1:2017. Applied Sciences, 14(3), 953. https://doi.org/10.3390/app14030953

